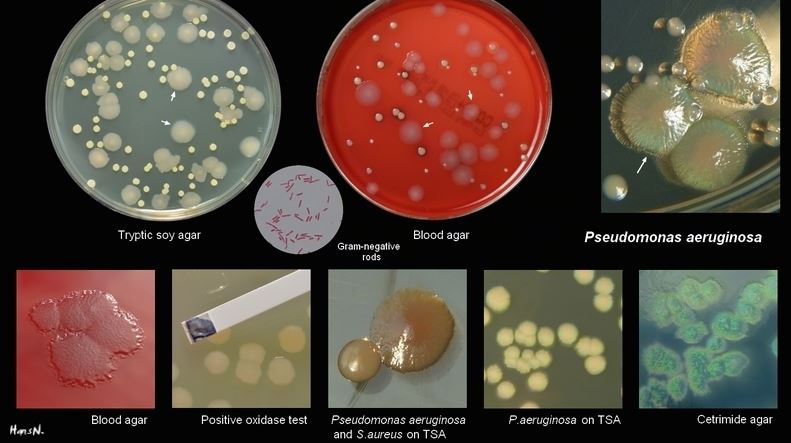

SINH VẬT HIẾU KHÍ LÀ GÌ? HƯỚNG DẪN PHÁT HIỆN VI KHUẨN HIẾU KHÍ BẰNG GIẤY TEST SUNCOLI (LOẠI 03)
Sinh vật hiếu khí là gì?
Sinh vật vi hiếu khí là một dạng vi sinh vật cần oxi để sống, nhưng lại yêu cầu lượng phần trăm oxi trong môi trường ít hơn trong khí quyển thông thường (>21% O2 nó sẽ không tồn tại được; thường sống ở khoảng 2–10% O2). Nhiều sinh vật hiếu khí chuộng ít cũng thuộc dạng sinh vật hiếu khí chuộng cacbon, yêu cầu một lượng cacbon dioxide đáng kể trong không khí (ví dụ, khoảng 10% trong trường hợp của loài Campylobacter).
Vi sinh vật hiếu khí có 4 loại được phân chia theo mục đích thực tế:
- Sinh vật hiếu khí bắt buộc: đây là loài vi sinh vật cần õi để phát triển, Những vi sinh vật sử dụng oxy để oxy hóa chất nền và tạo ra năng lượng.
- Sinh vật yếm khí tùy ý: không cà oxy để phát triển, tuy nhiên nếu xuất hiện oxy, chùng vẫn có thể sử dụng.
- Sinh vật hiếu khí chuộng ít cần cung cấp oxy cho sản xuất năng lượng nhưng tồn tại ở nồng độ khí quyển oxy.
- Sinh vật yếm khí không bắt buộc: không thể sử dụng oxy để tăng trưởng nhưng chịu được sự hiện diện của oxy.
Ý nghĩa vệ sinh về việc phát hiện vi khuẩn hiếu khí:
– Trong các nguồn nước thường có VK hiếu khí (VKHK).
– Tổng số VK hiếu khí bao gồm cả VK gây bệnh và VK không gây bệnh.
– Xét nghiệm tìm tổng số VK hiếu khí nhằm tìm hiểu độ nhiễm khuẩn nói chung của nước, qua đó đáng giá sơ bộ trạng thái vệ sinh nguồn nước.
– Về mặt dịch tễ, người ta không dựa vào số VKHK để kết luận nguồn nước đó có dùng được hay không.
Hướng dẫn phát hiện vi sinh vật hiếu khí bằng Giấy Phát Hiện Bacterria Vk Tổng Hiếu Khí (Loại 3) của Suncoli:
Bộ giấy thử này được dùng để xét nghiệm sàng lọc tổng vi khuẩn được quy định bởi bộ Luật vệ sinh Thực phẩm tại Nhật Bản. Nhằm mục đích phát hiện ra số lượng tổng vi khuẩn, bạn có thể nhân số lượng chấm đỏ xuát hiện trên giấy với hệ số tương ứng bên dưới (lượng vi khuẩn trong 1g hoặc 1ml).
Thông tin Sản phẩm Giấy phát hiện Vi khuẩn Hiếu Khí của Suncoli:
|
Phản ứng màu: |
Màu đỏ |
|
Nhiệt độ ủ: |
35-37 ºC |
|
Thời gian ủ: |
24 giờ |
|
Bảo quản: |
Trong bóng tối và mát |
|
Đóng gói: |
100 cái/hộp |
|
Hạn sử dụng: |
1 năm |
Hướng dẫn sử dụng Giấy phát hiện Vi khuẩn Hiếu Khí của Suncoli:
Ủ túi chứa mẫu thử ở 35-370C trong 24h rồi đọc kết quả:
Các vi khuẩn tổng số tạo thành các khuẩn lạc màu đỏ (như hình)
Cách tính số lượng vi khuẩn trong 1g hoặc 1 ml:
- Trong mẫu nước: số khuẩn lạc X 1
- Trong mẫu thực phẩm: số khuẩn lạc X 30
- Trên tay, dụng cụ, và thiết bị: số khuẩn lạc X 40
Các lưu ý khi sử dụng:
1) Trước khi thực hiện test, rửa kỹ đầu ngón tay của bạn và sau đó khử trùng kỹ bằng bông tẩm cồn.
2) Vì giấy hoàn toàn vô trùng (tiệt trùng), ngoại trừ phần trên của lỗ thủng. Không chạm trực tiếp.
3) Sau khi nhúng giấy vào mẫu, thả các giọt mẫu xuống tự nhiên (1 giấy test sẽ thấm khoản 1ml mẫu dung dịch, loại bỏ phần thừa bằng cách lắc nhẹ).
4) Đặt giấy vào túi ban đầu và dùng ngón tay ấn nhẹ từ trên cùng của túi để túi và giấy tiếp xúc gần nhau để loại bỏ không khí bên trong. Trong trường hợp này, lưu ý không ấn mẫu quá mạnh để mẫu trong giấy không bị trào ra khỏi túi.
5) Khi đếm khuẩn lạc đen sau khi nuôi cấy, giữ hơi trong túi và dùng bút lông để đánh dấu các khuẩn lạc xanh từ trên xuống. Trong trường hợp đó, khi đếm các khuẩn lạc bên trong tờ giấy, bạn có thể đếm các các khuẩn lạc bên trong bằng cách nhìn vào các tia sáng.
6) Khi chiếu tia UV, khó có thể nhìn thấy huỳnh quang trừ khi phòng tối, và trong một số ít trường hợp, nấm men có thể hình thành khuẩn lạc, nhưng khuẩn lạc có màu nâu và rất dễ phân biệt với cầu khuẩn màu vàng.
7) Vì sản phấm Suncoli nhậy cảm với anh ánh sáng và nhiệt độ nên bảo quản ở điều kiện tránh ánh sáng trực tiếp và môi trường mát mẻ ( Tủ lạnh).
8) Lưu mẫu: cho Alcohol hoặc cồn 70 vào giấy phát hiện trong túi để tránh nhiễm khuẩn. Khử trùng và bảo quản kết quả: Lấy ra khỏi túi, kẹp giữa 2 tờ giấy sấy khô tờ giấy mẫu (lưu ý không dùng nhiệt độ quá cao)
9) Xử lý mẫu sau khi sử dụng: bằng cách thiêu hủy hoặc hấp bỏ bằng nồi hấp tiệt trùng để tránh lây nhiễm.